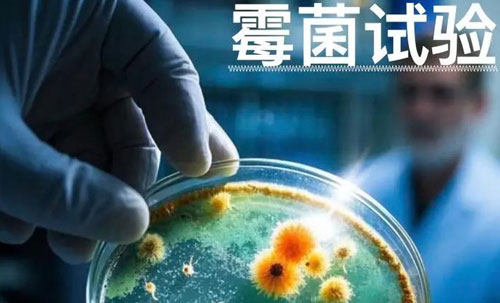
ù��ʵ����(����) ��ⱨ��, ���Ӳ�Ʒ��ù������Ի���

霉菌实验室(北京) 检测报告, 电子产品长霉试验测试机构
2025/12/19 13:54:25 阅读数:186 立即咨询
霉菌可以直接在许多有机材料上或材料中生长,由于材料表面有一层湿的菌丝体,便可以形成一个导电通路,这样会大大地降低绝缘材料的绝缘性能。潮湿的菌丝体也可以引起电子电路频率一阻抗性能的变化。
材料表面的霉菌可以产生酸和电解质,这些物质会腐蚀产品,使材料电解、老化,引起短路甚至电气性能失效。即使玻璃,也会由于这种腐蚀作用而使透明度明显地降低。 消防电子产品长霉试验可确定消防电子产品在潮湿的长霉条件下贮存及使用的适应性。
IEC 60068-2-10标准旨在评估电工电子产品在霉菌影响下的抗力性能。该标准详细规定了模拟自然环境中霉菌生长条件的实验方法,以便了解和预测产品在实际使用过程中对霉菌的抵抗能力。
霉菌试验方法
1、培养条件为温度(29±1)℃,相对湿度90%~100%。对于小件试验样品,接种后将试验样品和3个对照条分开间距放置在容器内,并把容器放在培养箱中;阴性对照样品应放置在与存放试验样品的容器相同但无菌的容器中,不放置对照条,并将容器放在培养箱中。
2、对于容器不能容纳的大件试验样品,接种以后将对照条和试验样品一起放在培养箱中,阴性对照样品应放置在单独专用,经过消毒的试验箱中。
总的来说,IEC 60068-2-10霉菌试验标准对电工电子产品的质量控制具有重要作用。通过该标准的测试,制造商可以更有效地评估和改进产品的抗霉菌性能,从而为消费者提供更安全、更可靠的产品。
霉菌试验范围
1、火灾报警设备:火灾报警触发器件、 火灾报警控制装置、火灾警报装置、消防联动控制设备;等。
2、报警阀:湿式报警阀、干式报警阀、雨淋报警阀、预作用装置、延迟器、水力传感器、水力警铃等。
3、消防通信设备:火警调度机、消防指挥调度设备、消防车辆动态管理装置等。
![[news:title]](/images/swxgzh.jpg)
检测找彭工,咨询电话:13691093503